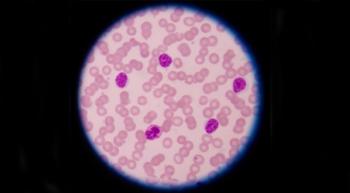

CLL
Latest News
Latest Videos

More News

On Thursday, September 30, 2020, from 5:30 – 6:30 p.m. ET join CURE® for the next EDUCATED PATIENT® CLL Webinar.

Allogeneic hematopoietic stem cell transplant’s role in the chronic lymphocytic leukemia has changed due to new novel agents, but research shows its still effective despite novel agent exposure.

An early phase 1b/2 study of Copiktra in combination of standard of care shows how the treatment is active for patients with chronic lymphocytic leukemia but further study is needed to ensure it is an effective and safe alternative to standard of care.

Arzerra will be available at no cost to patients via an oncology patient access program which will be facilitated through Patient Access Novartis Oncology.





WellBe, a new voice-enabled virtual assistant, can remind patients with cancer to take their medication and keep them on track from the comfort of their own home.

Dr. Othman Al-Sawaf discusses the encouraging long-term data that makes the Venclexta-Gazyva combination a viable treatment option for patients with CLL.

“Final results from ASCEND confirm the findings of the interim analysis and support the favorable efficacy and safety of (Calquence) versus standard-of-care regimens in relapsed or refractory CLL,” said Dr. Paolo Ghia.

A clinical trial of Brukinsa (zanubrutinib) is open to patients with B-cell blood cancers and will determine whether the side effects re-emerge with Brukinsa.

A list of the recent trial initiations that occurred within the cancer space in July.

A three-drug treatment sparked complete responses in more than half of patients with high-risk chronic lymphocytic leukemia, who also tolerated the regimen well.

“If I only have one tool to treat the disease, I will play with that tool in many different ways. But if I have access to four different tools, then I will give up tool (number) one if I don't feel it's working,” explained Dr. Mazyar Shadman of the Seattle Cancer Care Alliance, about his approach to treating high-risk chronic lymphocytic leukemia in an interview with CURE®.

“There’s a lot of work to do in CLL,” said Dr. Mazyar Shadman about the treatments currently being investigated in CLL. “We have been very fortunate to be able to provide a lot of options to our patients, but we shouldn't forget that there's a long way to go.”

In an interview with CURE®, Dr. Mazyar Shadman discussed ways that patients with chronic lymphocytic leukemia can play a role in ensuring that they are able to reap the benefits of treatment.

In an interview with CURE®, Dr. Mazyar Shadman discussed the enormous variety of treatment preferences among patients with CLL and said that emphasis should be placed on treating each person according to their wishes.

There are three things that should be considered when deciding what is the optimal treatment in the first line setting for patients with chronic lymphocytic leukemia (CLL), according to Dr. Mazyar Shadman.

Here is a list of the recent trial initiations that occurred within the cancer space in June.
Regulation changes could eliminate barriers to potentially lifesaving CAR-T cell immunotherapy for patients covered by Medicare or Medicaid.

From a study showing a popular cancer side effect management steroid decreasing the risk of death for patients in the hospital with COVID-19 to a new liquid biopsy test detecting lingering cancer in DNA, here’s what’s making the headlines in the cancer space this week.

Here is a roundup of the latest news and updates for patients with Chronic Lymphocytic Leukemia from CURE.

“The superior efficacy of venetoclax-obinutuzumab has been observed and maintained in the current follow up,” Dr. Othman Al-Sawaf, of University Hospital of Cologne in Germany, said during a pre-recording presentation at the 2020 ASCO Virtual Scientific Program.

“Collectively, these results support acalabrutinib (Calquence) use in upfront CLL,” said Dr. John C. Byrd. “This is compounded and supported by two additional phase III studies that have been completed with this agent.”















